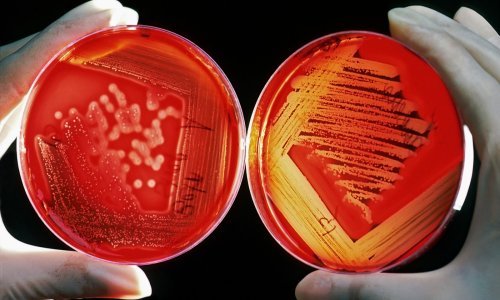
Najnovije istraživanje moglo bi promijeniti način na koji možemo otkriti rak, ali i kako ga liječimo, i sve to zbog gljivica

Svjetska zdravstvena organizacija (WHO) sastavila je prvi popis gljivičnih patogena koji predstavljaju najveću prijetnju ljudskom zdravlju, upozoravajući da su neki sojevi sve otporniji na lijekove i sve su rašireniji
Tijelo UN-a, koje ima slične popise za viruse i bakterije, objavilo je da gljivične infekcije i njihova sve veća otpornost na liječenje predstavljaju sve veći rizik. Povijesni nedostatak fokusa na opasnost gljivičnih patogena znači da postoje velike praznine u znanju, kao i manjkavosti u praćenju, liječenju i dijagnostici.
Bilo je teško čak i procijeniti razmjere prijetnje zbog nedostatka podataka, navodi WHO, pozivajući vlade i znanstvenike na velike napore da pojačaju odgovor na 19 gljivičnih infekcija s popisa.
'Izlazeći iz sjene pandemije bakterijske antimikrobne rezistencije, gljivične infekcije šire se i sve su otpornije na liječenje, postajući javnozdravstveni problem u cijelom svijetu', rekao je dr. Hanan Balkhy, pomoćnik glavnog direktora WHO-a za antimikrobnu rezistenciju.
Gljivične infekcije često pogađaju ljude koji su već teško bolesni, poput pacijenata oboljelih od raka ili tuberkuloze, a stope su skočile među hospitaliziranim pacijentima s covidom tijekom pandemije. Postoje samo četiri vrste liječenja, s vrlo malo novih opcija u razvoju.
Klimatske promjene također znače da se učestalost i zemljopisni raspon patogena širi, ističe WHO. Otpornost je djelomično uzrokovana pretjeranom upotrebom antimikotika u poljoprivredi. Popis dijeli patogene u tri kategorije na temelju njihova potencijalnog utjecaja i podataka o riziku njihove otpornosti: kritični, visoki i srednji prioritet.
Skupina kritičnog prioriteta uključuje Candidu auris, a koja je vrlo otporna na lijekove i izazvala je brojne epidemije u bolnicama diljem svijeta, kao i Cryptococcus neoformans, Aspergillus fumigatus i Candidu albicans.
Skupina visokog prioriteta uključuje brojne druge gljivice iz obitelji Candida, kao i druge, poput Mucorales, skupine koja sadrži gljivice što uzrokuju mukormikozu ili 'crnu gljivicu', infekciju koja se brzo proširila kod teško bolesnih ljudi - osobito u Indiji - tijekom epidemije covida. Skupina srednjeg prioriteta obuhvaća brojne druge gljivice, uključujući Coccidioides spp i Cryptococcus gattii.